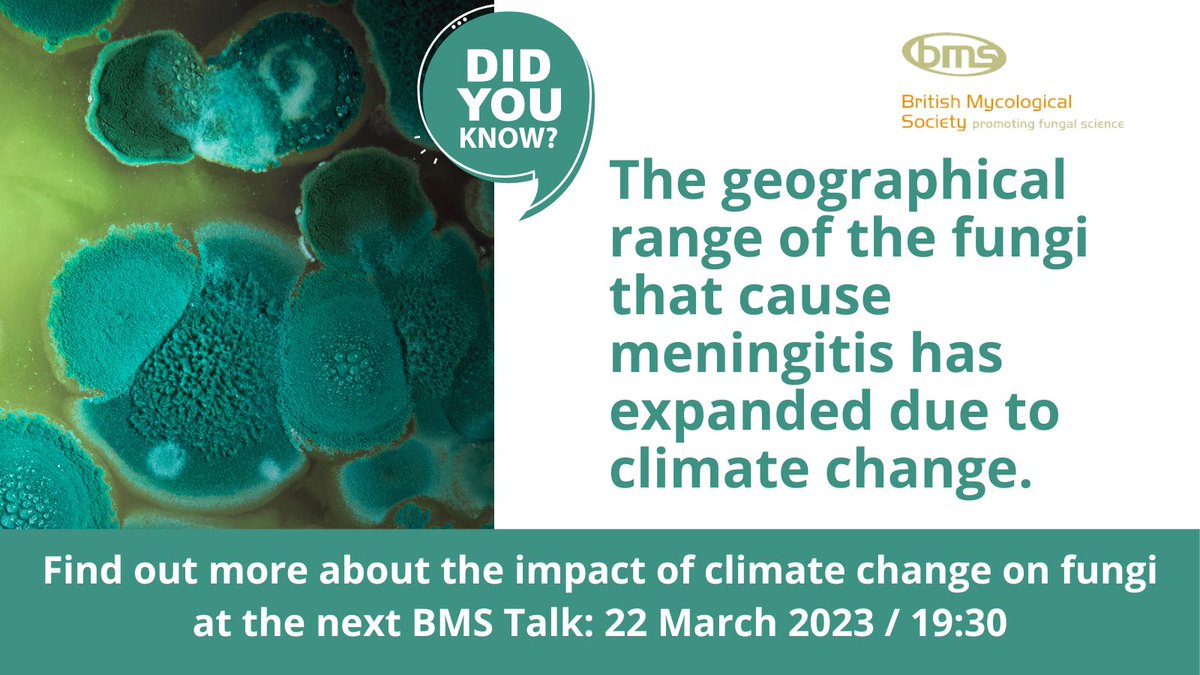
Just one week to go until @dwdenning tells us how climate change has affected the spread of fungal pathogens. Don't miss this BMS Talk: 22 March at 19:30. Online, free, and all are welcome: britmycolsoc.org.uk

katwrite
@lakatwriter
Actor, film maker, writer - passionate about all these things.
humanagency.co.nz/actor-profile/…
ID: 4445147727
http://www.imdb.com/name/nm0358003/?ref_=fn_al_nm_1 11-12-2015 05:34:08
212 Tweet
175 Followers
1,1K Following

Just spent a lovely few days playing a little but meaningful role on No Exit with a kind and generous group of actresses and actor, with the gracious, talented director Damien Power - thank you Stu Turner & Scott Frank for this opportunity.





This was a lovely experience doing a small but wonderful little role/couple of days on the very talented @damienjpower's film No Exit. Thank you Damien and Scott. Scott Frank youtube.com/watch?v=GFvupy… #actorslife #film #Thriller #NewZealand #actress





With the devastating news that Roe v. Wade has been overturned, Justin LaLiberty has created a list "fifty years of roe v wade, a century of abortion in cinema". View the full list of titles here: boxd.it/h791A


Lynnaire MacDonald Save Me Short Film This is getting exciting.






Register for our next #webinar on the growing threat of #fungalinfections- hurdles we face w/ their dx & treatment & opportunities for change. RDA VMMC & Safdarjung Hospital The University of Manchester @dwdenning Instituto de Salud Carlos III (ISCIII) Hatim Sati World Health Organization (WHO) 🗓️: June 8 🕐:13:00 GMT 18:30 IST Register here: ow.ly/gyrN50OxGuZ